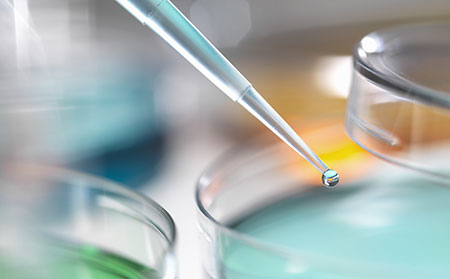
牛皮膚癬接種新冠病毒疫苗

牛皮膚癬患者接種新冠病毒疫苗前中后需要知道的幾個事兒
新冠病毒疫苗預防接種一直是我們近期嚴峻對待的一件事情,在疫苗接種的過程中,發生了許多問題,同樣,來濰坊銀屑病醫院就診的患者也產生了同一類的問題,我們一起來看看吧。
接種疫苗后為什么少數人有不良反應?牛皮膚癬患者要注意什么?
疫苗接種后,在誘導人體免疫系統產生對特定疾病的保護力的同時,由于疫苗本身的生物學特性,以及受種者個體之間的差異,有少數受種者在接種后可能會發生不良反應。

新冠病毒疫苗接種不良反應主要有哪些?
從前期新冠病毒疫苗臨床試驗研究結果、緊急使用期間和附條件上市后大規模人群使用收集到的信息看,我們的新冠病毒疫苗具有良好的安全性。
新冠病毒疫苗不良反應中的一般反應,主要表現為接種部位紅腫、硬結、疼痛等局部反應,發熱、乏力、頭痛等全身反應,是一過性的、輕微的機體反應,通常不需要治療。
從前期新冠病毒疫苗臨床試驗研究結果、緊急使用期間和附條件上市后大規模人群使用收集到的信息看,我國新冠病毒疫苗常見不良反應的發生情況與已廣泛應用的其他疫苗基本類似,絕大多數為一般反應。
新冠病毒疫苗不良反應中的異常反應,主要指造成受種者的器官或功能損害的相關反應,常表現為急性嚴重過敏性反應等,極少發生,需要及時就診治療。
牛皮膚癬患者在接種前新冠病毒疫苗要知道什么?
接種疫苗前要注意評估身體的狀況,確保不處于感冒階段,或者是腹瀉階段以及皮膚過敏反應階段,也就是在身體狀況比較好的情況下進行接種疫苗。
另外,要注意接種哪一類的疫苗。如果是口服制劑,還需要空腹。接種疫苗后注意體溫變化,因為有些疫苗接種后可能會出現低熱的現象,但是一般不會超過三天。
如果出現高熱的情況,且癥狀持續時間比較久,就需要就診。另外,接種疫苗后還要注意接種部位有沒有化膿、紅腫等感染跡象,需要注意有無皮膚過敏反應等情況的出現。

牛皮膚癬患者在接種新冠病毒疫苗時需要注意些什么呢?
1、近期有發熱、咽痛、咳嗽、急性感染癥狀暫緩接種疫苗。
2、有蕁麻疹、哮喘或者蛋白質過敏者需慎重接種疫苗,特別是既往接種疫苗后出現發熱,蕁麻疹等過敏表現的,不要接種疫苗。
3、使用類固醇和免疫抑制劑者需暫緩接種疫苗。
4、妊娠期不要接種疫苗。
5、接種疫苗時需注意疫苗是否在有效期,是否有渾濁,沉淀等變質表現。
6、接種疫苗后忌飲酒、忌濃茶、咖啡,忌劇烈運動,宜清淡飲食,注意休息。
牛皮膚癬患者接種新冠病毒疫苗時要怎么做?
接種時,向醫生主動提供自己的健康狀況、近期服用的藥物信息,并如實填寫知情同意書;如果接種部位有傷口,盡量避開傷口選擇另一側接種;止血棉簽丟入醫療垃圾桶或黃色醫療廢物垃圾袋中。
牛皮膚癬患者接種新冠病毒疫苗后還要做什么?
接種之后,要在接種現場留觀30分鐘,沒有異常情況才可以離開?;丶液笕绯霈F發燒不退或持續不舒服,要向接種點報告并及時就醫。
濰坊東方銀屑病研究院指出,牛皮膚癬患者需要了解新冠病毒疫苗接種相關知識,了解接種點的接種流程;確定是否需要提前預約;按要求帶好身份證;接種當天穿寬松的衣服方便接種;出門時戴上口罩。
【具體治療方案可咨詢濰坊東方銀屑病研究院,謹遵醫囑,切勿自行用藥。如果您無法確定自身病情,可點擊右側咨詢窗口,或撥打我院電話0536-3087125,提供自己的皮膚病照片,我們會為您識別并提供相關治療建議?!?/p>
- ·牛皮膚癬與炎癥之間的關系,這些食物幫助抗炎!
- ·牛皮膚癬缺乏維生素d的主要表現及維生素d對牛...
- ·早期輕度女性頭皮牛皮膚癬癥狀圖片表現怎么治療
- ·【濰坊東方醫院不坑人】牛皮膚癬有什么治療方法
- ·【濰坊東方醫院大曝光】牛皮膚癬應該怎么治療?
- ·【濰坊東方醫院不宰人】怎樣治療牛皮膚癬花錢少
- ·2022年牛皮膚癬新藥和治療方法的進展
- ·牛皮膚癬腳踝鱗屑厚影響大嗎及并發癥
- ·過敏性皮炎與牛皮膚癬不同部位的癥狀對比,怎么...
- ·艾滋病和牛皮膚癬有什么關聯?艾滋病患者如何治...
- ·滴狀牛皮膚癬的圖片癥狀,怎么治療及會不會自愈
- ·真實的牛皮膚癬和神經性皮炎癥狀對比怎么區別及...
- ·真實的牛皮膚癬和玫瑰糠疹圖片對比癥狀區別,發...
- ·真實的牛皮膚癬和脂溢性皮炎癥狀對比圖片,發病...
- ·[濰坊東方銀屑病醫院地圖]牛皮膚癬治療方法是...
- ·[濰坊東方銀屑病醫院公交]牛皮膚癬怎么治療不...
- ·牛皮膚癬指甲變形翹起癥狀圖片及如何治療
- ·指甲牛皮膚癬病變原因/圖片癥狀?要不要剪掉病...
- ·點滴狀牛皮膚癬:癥狀圖片,引起原因,治療用藥...
- ·指甲牛皮膚癬早期和后期的圖片癥狀特征及如何護...





